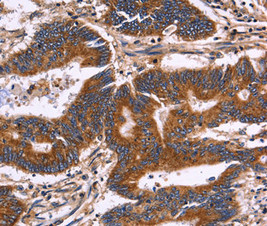

KIR2DL3 Antibody
-
中文名稱:KIR2DL3兔多克隆抗體
-
貨號:CSB-PA913411
-
規格:¥2024
-
圖片:
-
其他:
產品詳情
-
產品名稱:Rabbit anti-Homo sapiens (Human) KIR2DL3 Polyclonal antibody
-
Uniprot No.:
-
基因名:
-
別名:KIR2DL3; CD158B2; KIRCL23; NKAT2; Killer cell immunoglobulin-like receptor 2DL3; CD158 antigen-like family member B2; KIR-023GB; Killer inhibitory receptor cl 2-3; MHC class I NK cell receptor; NKAT2a; NKAT2b; Natural killer-associated transcript 2; NKAT-2; p58 natural killer cell receptor clone CL-6; p58 NK receptor CL-6; p58.2 MHC class-I-specific NK receptor; CD antigen CD158b2
-
宿主:Rabbit
-
反應種屬:Human,Mouse,Rat
-
免疫原:Fusion protein corresponding to a region derived from internal residues of Human killer cell immunoglobulin-like receptor, two domains, long cytoplasmic tail, 3/1/4/ short cytoplasmic tail, 4
-
免疫原種屬:Homo sapiens (Human)
-
克隆類型:Polyclonal
-
純化方式:Antigen Affinity Purified
-
濃度:It differs from different batches. Please contact us to confirm it.
-
產品提供形式:Liquid
-
應用范圍:ELISA,IHC
-
推薦稀釋比:
Application Recommended Dilution IHC 1:50-1:100 -
Protocols:
-
儲存條件:Upon receipt, store at -20°C or -80°C. Avoid repeated freeze.
-
貨期:Basically, we can dispatch the products out in 1-3 working days after receiving your orders. Delivery time maybe differs from different purchasing way or location, please kindly consult your local distributors for specific delivery time.
-
用途:For Research Use Only. Not for use in diagnostic or therapeutic procedures.
相關產品
靶點詳情
-
功能:Receptor on natural killer (NK) cells for HLA-C alleles (HLA-Cw1, HLA-Cw3 and HLA-Cw7). Inhibits the activity of NK cells thus preventing cell lysis.
-
基因功能參考文獻:
- These results suggest a detrimental role of HLA-A-Bw4 and HLA-C2 groups, which are associated with the development of chronic hepatitis B, and a protective role of KIR2DL3. PMID: 28211154
- A minority (21%) of HLA-B( *)46:01 peptides, with common C-terminal characteristics, form ligands for KIR2DL3. PMID: 28514659
- These results show that 2DL3(+) NK cells are mediators of HIV-specific responses. Furthermore, responses of NK cell populations to iCD4 are influenced not only by NK cell education through specific KIR/HLA pairs, but also by differential HIV-mediated changes in HLA expression. PMID: 27506421
- Results identified three SNPs (S320F, H245Y, and H77Y) as highly deleterious in KIR2DL3 and nine SNPs (R157Q, H156Y, S63L, R157 W, F179 V, H128R, T101 M, R180C and F176I) in case of IFNL3, in coding region only with high conservation ranks highlighting the functional SNPs on phenotypic variability and disease susceptibility on HCV clearance candidate genes. PMID: 27461217
- gene polymorphism is associated with Crohn's disease in Spanish patients PMID: 26542067
- study compared KIR gene repertoire of HIV-1 positive with exposed uninfected (EU)) infants to elucidate its association with transmission; results revealed presence of significantly high frequencies of activating gene KIR 2DS5 and inhibitory gene KIR 2DL3 in EU infants as compared to HIV-1 positive infants PMID: 26255774
- The authors have identified a deleterious effect of the KIR2DL3-HLA-C1 receptor-ligand combination on HIV clinical outcomes in a Thai cohort. PMID: 26372271
- Single Nucleotide Polymorphism in KIR2DL3 gene is associated with Asthma and Atopic Dermatitis. PMID: 26430804
- KIR2DL3 has previously been identified as important for clearance of the Hepatitis C virus after established infection,not found to be relevant to resistance to Hepatitis C infection. PMID: 24845613
- CD4(+) CD28(-) cells exhibited increased KIR2DS2, reduced KIR2DL3 and increased DAP12 expression in HD-ESRD compared with NDD-CKD patients. PMID: 25484131
- KIR2DL3 and KIR3DS1 genes could be protector genes and immuno-genetic markers for Hepatits B in the Turkish population. PMID: 24407110
- Higher frequency of CD158b+ natural killer cells combined with fewer activated NK cells may be associated with HCV-related chronic inflammation. PMID: 23813131
- Low frequency of KIR2DL3 is associated with nodular melanoma and in ulcerated melanoma. PMID: 23370861
- Gene frequency of KIR2DL3 is lower in subjects with rheumatoid arthritis than in control. PMID: 22960345
- Our study indicates that the absence of the inhibitory KIR2DL3 gene is associated with an increased risk of developing multiple sclerosis in individuals carrying HLA-C1 alleles PMID: 22185807
- Substitutions restricted to activating KIR all reduce the avidity of KIR2DL1 and KIR2DL3, further evidence that activating KIR function often becomes subject to selective attenuation. PMID: 22772445
- These results suggest that natural selection has reduced the frequency of the KIR2DL3-HLA-C1 combination in malaria high-endemic population. PMID: 22412373
- We found an increase in the KIR A haplotype in tuberculosis patients compared to controls, and only KIR 2DL3 was found to be significantly more prevalent among TB patients PMID: 22118180
- KIR2DL3, KIR2DS5 and KIR2DL5B genes may be correlated with pathogenesis of nasopharyngeal carcinoma in the Chinese southern Han population. PMID: 21729574
- Carriage of specific KIR genes in combination with specific HLA-C and IL28B variants was associated with an altered HCV treatment response. PMID: 21931540
- indicated nonspecific stimulation of natural killers, probably mediated by an increase in serum concentration of heat shock protein with a molecular weight of 70 kDa PMID: 21165439
- Data shoe that KIR2DL3-C1C2 combination was near-significantly associated with HAM/TSP outcome in the second stage. PMID: 20483367
- Despite its particular monoclonal antibody reactivity, the specificity of KIR2DL3*005 for HLA-C molecules does not differ from that of other KIR2DL2/L3 alleles. PMID: 20525888
- decidual CD4+ and CD8+ T cells contain increased proportions of KIR2DL3+ cells compared to peripheral blood PMID: 19394706
- KIR and HLA-C protection in both treatment response and spontaneously resolving HCV was validated at the allelic level, in which KIR2DL3-HLA-Cw*03 was associated with sustained virological response (SVR)(P = 0.004, OR = 3.4, 95% CI = 1.5-8.7). PMID: 20077564
- HLA-Cw7 zygosity affects the size of a subset of CD158b+ natural killer cells. PMID: 11958591
- Positive linkage disequilibrium was seen between KRI2DL1 and KIR2DL3.Individuals were subgrouped according to the major HLA-C encoded KIR-epitopes (group C1 versus C2). C2 individuals transcribe RNA from KIR2DL2 genes without specific HLA-C ligands. PMID: 12559621
- Decreased expression of NKB1 and GL183 on natural killer (NK) cells in endometrium, but not in myometrium, in women with adenomyosis. May be compensatory effect in which NK cytotoxicity is activated to eradicate abnormal endometrial cells. (GL183) PMID: 15217996
- The modulated expression of KIR by IL-2 and TGF-beta can be associated with the changed NK-cytotoxic target-discriminating ability of NK cells upon their exposure to IL-2 and TGF-beta. PMID: 15227739
- results show that genes encoding the inhibitory NK cell receptor KIR2DL3 and its human leukocyte antigen C group 1 (HLA-C1) ligand directly influence resolution of hepatitis C virus (HCV) infection PMID: 15297676
- donor killer immunoglobulin-like receptor (KIR) genotype-patient KIR ligand combination (Mismatch) and no antithymocyte globulin preadministration are critical factors for the adverse effects of allogeneic stem cell transplantation PMID: 18158964
- In contrast to natural killer (NK) cells, the functions of killer inhibitory receptors in CD4+ T lymphocytes might derive from a selective expression of their activating or inhibiting (CD158b2) forms. PMID: 18292496
- Allelic polymorphism at sites distal to the ligand-binding site of KIR2DL3 has diversified this receptor's interactions with HLA-C. No cytotoxic interaction between the HLA-C epitope and KIR2DL3 receptor is observed compared to that of KIR2DL2 and HLA-C. PMID: 18322206
- Some KIR-HLA genotypes could be associated to the development of clinical forms of leprosy. PMID: 18778326
- Support role for KIR2DL3 receptor in determining severity of hepatitis C virus recurrence after liver transplantation. PMID: 19326408
- This study provides an estimate of the minimal KIR-HLA system essential for long-term survival of a human population. PMID: 19837691
顯示更多
收起更多
-
亞細胞定位:Cell membrane; Single-pass type I membrane protein.
-
蛋白家族:Immunoglobulin superfamily
-
數據庫鏈接:
Most popular with customers
-
YWHAB Recombinant Monoclonal Antibody
Applications: ELISA, WB, IHC, IF, FC
Species Reactivity: Human, Mouse, Rat
-
Phospho-YAP1 (S127) Recombinant Monoclonal Antibody
Applications: ELISA, WB, IHC
Species Reactivity: Human
-
-
-
-
-
-